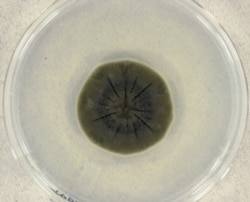
Cladosporium sphaerospermum – той самий чорнобильський грибок – в чашці Петрі

Більшість людей вже хочуть забути все, що сталося в 2020 році, проте під завалом неприємних заголовків загубилося і кілька хороших новин. І хто знає, може саме вони змінять світ на краще.
Нове джерело енергії: термоядерний синтез змінить світ
Мрії учених про чисті термоядерні реактори, здатні живити міста, стали трохи ближче до реальності в серпні, коли президент Франції Еммануель Макрон оголосив про початок створення Міжнародного термоядерного експериментального реактора (ITER).
Керований ядерний синтез може стати революцією у світовій енергетиці. На відміну від реакції поділу ядра, коли атоми розщеплюються, виділяючи енергію, яка здатна зрівняти з землею Хіросіму, при ядерному злитті нагріті частинки у вакуумі зіштовхуються, об'єднуючись у більший атом. Отримана таким чином енергія не пов'язана з викидами шкідливих речовин і при цьому практично нескінченна. Палива для такої реакції потрібно небагато, і частину його можна добувати з морської води.
Про проект ITER вперше заговорив радянський лідер Михайло Горбачов у бесіді з президентом США Рональдом Рейганом у 1985 році. Відтоді до нього приєдналися інші країни і були інвестовані колосальні суми. Перший тест реактора ITER намічений на 2025 рік.
Неспішний розвиток проекту підштовхнув інші організації поекспериментувати з камерами термоядерного синтезу, теоретичне обґрунтування якого було запропоновано радянськими вченими ще в 1950-і роки. Так чи інакше, у разі успіху, проблема доступності енергії для людства може бути вирішена в найближчому майбутньому.
Чорнобильський грибок рятує від космічної радіації
У серпні вчені зі Стенфорду і Університету Північної Кароліни опублікували статтю про те, що грибок, який виріс в Чорнобилі, може допомогти космонавтам висадитися на Марс і навіть жити там в безпеці.
Ці дані з'явилися після того, як вчені, які побували на Чорнобильській АЕС, звернули увагу на непривабливий чорний грибок, що розрісся всередині опроміненої зони.
Подальші дослідження показали, що грибок-екстремал здатний переробляти радіацію в енергію, що дозволяє йому процвітати на АЕС. Подібний потяг до радіації наштовхнув вчених на думку відправити зразок цього грибка на Міжнародну космічну станцію.
Однією із головних перешкод для висадки людини на Марс є космічна радіація, з якою космонавти стикаються за межами атмосфери Землі. Тому НАСА було вкрай зацікавлене в тому, щоб подивитися, як радіотрофний гриб поведеться в космосі.
Всередині МКС над датчиком радіації підготували «галявину» для Cladosporium sphaerospermum завтовшки 1,7 мм. Грибок поглинув 2% радіації на МКС. Цей результат може здатися скромним, проте стаття викликала фурор в наукових колах, тому що там дійшли висновку, що якщо збільшити товщину грибкового шару до 21 см, він практично повністю захистить космонавтів від радіації.
Особливо перспективна ця знахідка в зв'язку з тим, що таку плісняву можна виростити на Марсі або на борту космічного корабля, що прямує до «червоної планети».
«Деревне цунамі» в Пакистані тримає робочих на плаву
Близько 60 000 пакистанців, які залишилися без роботи і часто без засобів до існування через карантинні заходи, знайшли себе у новій справі – висаджуванні дерев.
Ініціатива щодо відновлення пакистанських лісів і висаджуванні 10 мільярдів дерев із 2018 до 2023 рік заглохла з початком пандемії, як і вся економіка країни.
Однак рішення влади призупинити висадку дерев незабаром було скасовано, і відправлені в неоплачувану відпустку робітникиі знову взялися за справу.
Робітники, яким загрожувала голодна смерть, тепер щодня отримують невелику зарплатню у 500 рупій (близько трьох доларів).
Один з озеленювачів розповів кореспонденту агентства «Reuters»: «Через коронавірус міста закрилися і роботи не стало. Багато з нас втратили можливість заробити собі на життя». Ініціатива по висадці дерев, за його словами, означає, що «всі ми знову можемо отримувати щоденну зарплату і прогодувати наші сім'ї».
Пофарбований вітряк виявився значно безпечнішим для птахів
Норвезькі вчені знайшли простий спосіб запобігти смерті багатьох тисяч птахів, що гинуть щороку від лопатей вітряних млинів.
У липні була опублікована стаття, заснована на багаторічних дослідженнях на вітряній фермі в Смьоле у Норвегії. У статті йдеться про те, що кількість загиблих птахів різко скоротилося після фарбування в чорний колір однієї з лопатей на деяких вітрогенераторах.
Смерть птахів – один з найбільш емоційних аргументів проти вітроенергетики. Птахи особливо беззахисні перед млином, який швидко крутиться, і який в туманні дні не відрізняється для них від навколишнього неба. На фермі в Смьоле до початку досліджень загинуло кілька орланів-білохвостів.
Використовуючи службових собак, щоб знайти кістки птахів, вчені встановили, що після фарбування лопатей кількість загиблих птахів скоротилося на 70%. Очевидно, фарба робить їх більш помітними для птахів, і ті облітають небезпечну зону.
Ще належить встановити, чи не є ці результати специфічними для конкретної місцевості і видів птахів. Вітряні ферми в ПАР і Нідерландах готуються повторити цей експеримент.
В'єтнам успішно бореться з незаконною торгівлею дикими тваринами
Вже після початку пандемії коронавірусу, джерело якої, за деякими даними, походить із сумнозвісного «мокрого ринку» диких тварин у Китаї, В'єтнам почав активну боротьбу з незаконною торгівлею тваринами. Раніше В'єтнам вважався одним з основних перевалочних пунктів такої торгівлі.
У липні світові новинні агентства повідомили як сенсацію, що В'єтнам вводить заборону на торгівлю дикими тваринами, щоб знизити ризик спалахів нових захворювань у майбутньому.
Експерти всередині країни говорять, що це не так: уряд просто закликав більш активно виконувати вже чинні закони. Однак на тлі пандемії цей заклик не здається порожньою риторикою.
За даними екологів, за останні два роки у В'єтнамі затримання браконьєрів зросли на 44% відсотки, а в 2020 році 97% затриманих контрабандистів були заарештовані. Покарання за торгівлю дикими тваринами також значно збільшилися.